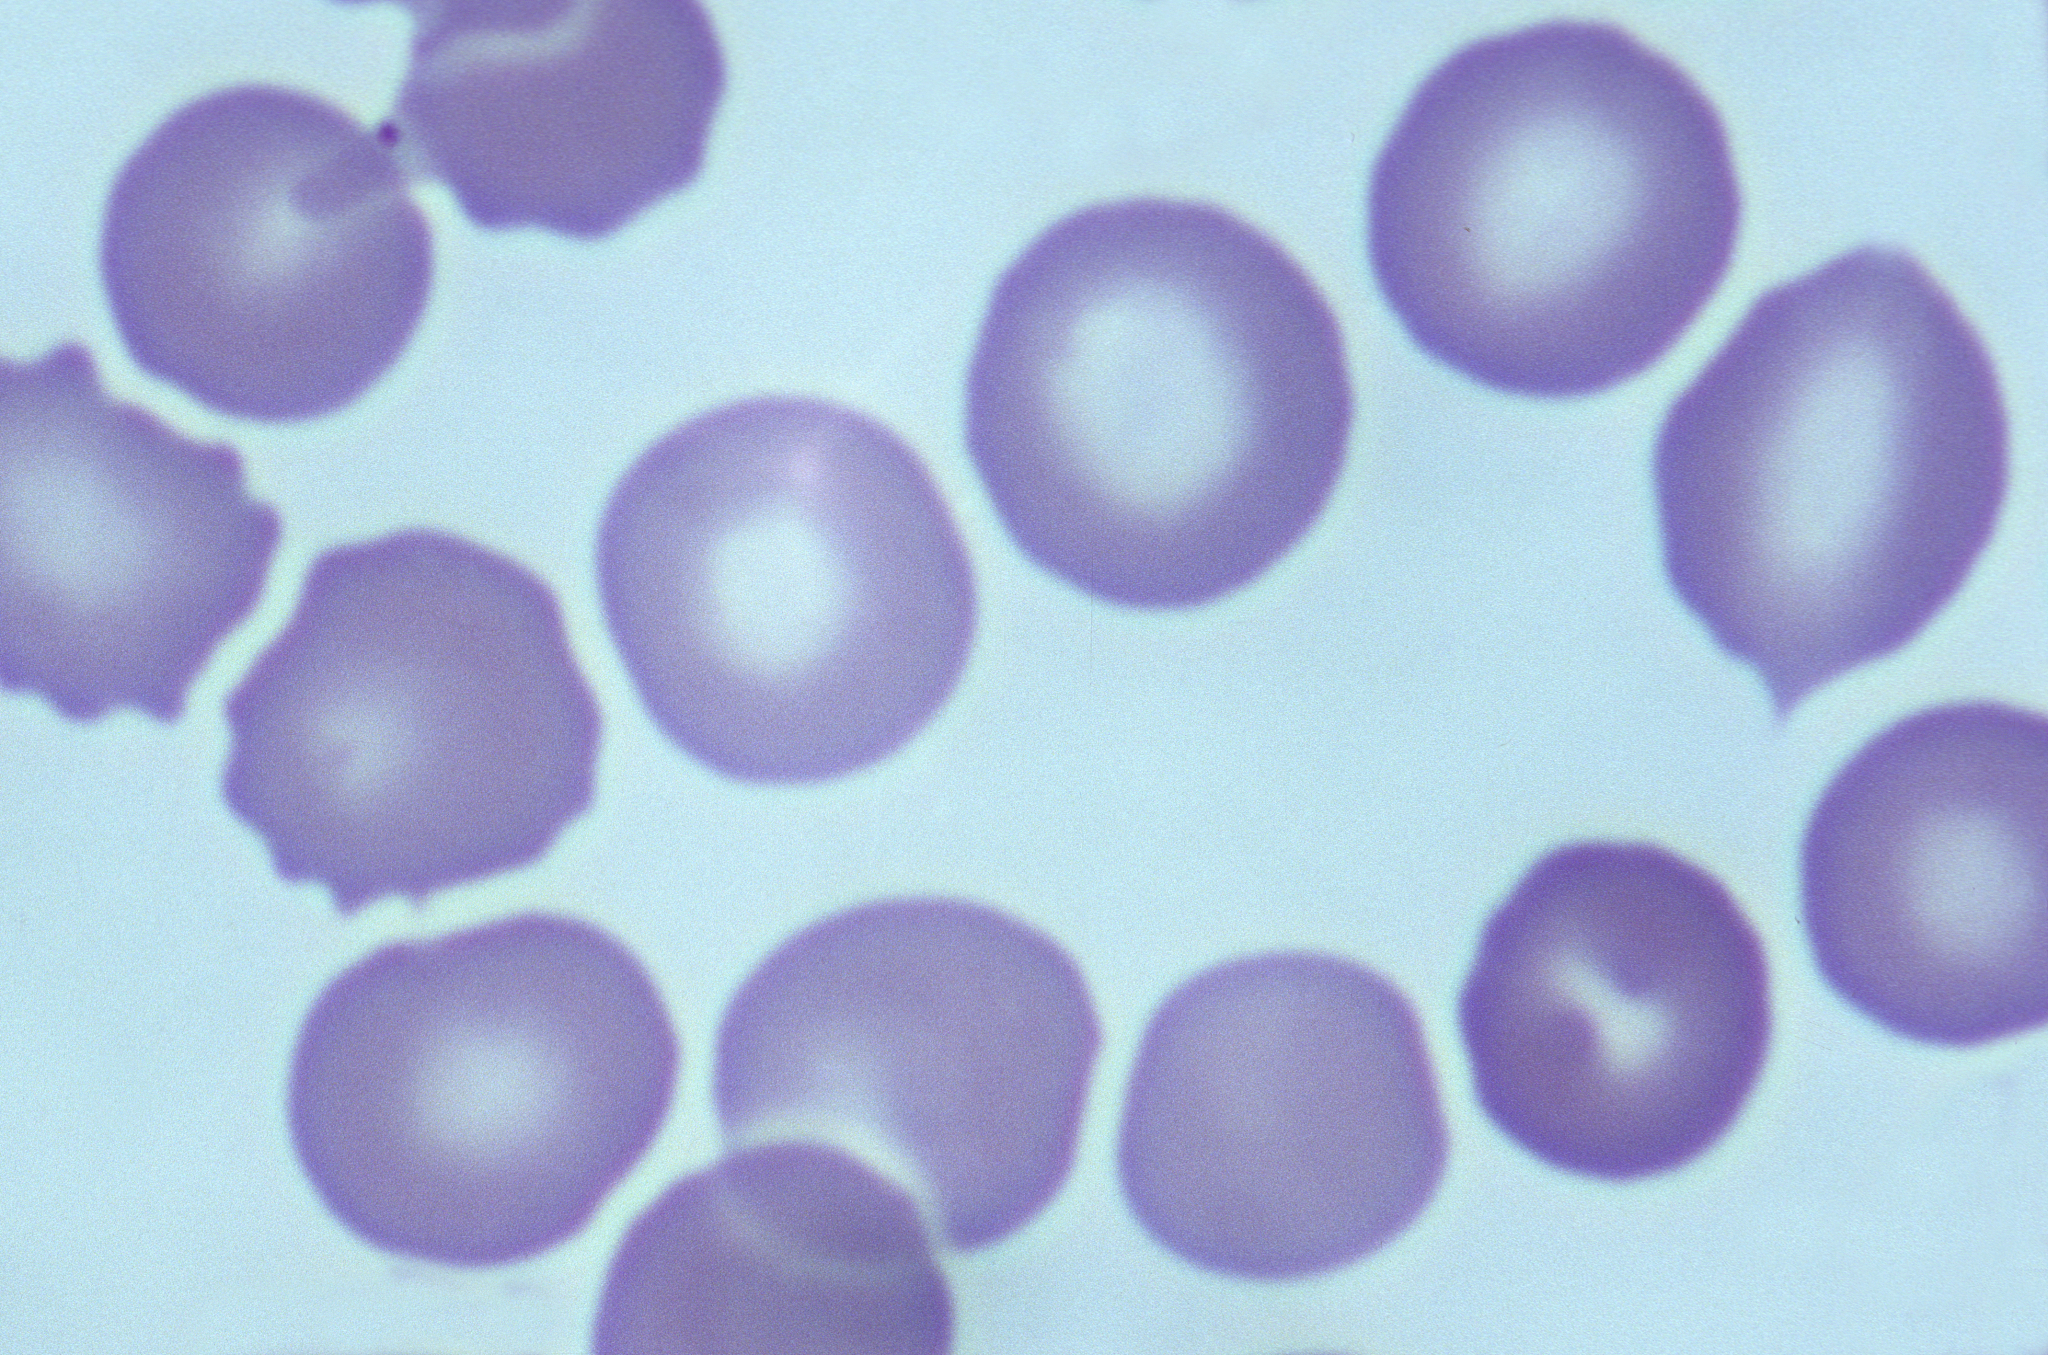
如何预防缺铁性贫血？

如何预防缺铁性贫血?
预防缺铁性贫血的方法包括:
-
饮食均衡:确保摄入足够的富含铁质的食物,如瘦肉、蛋、豆类、绿叶蔬菜等。同时,维持适当的蛋白质、维生素C和叶酸摄入,可以促进铁的吸收和利用。
-
避免食物相互干扰:某些食物可能会干扰铁的吸收,如咖啡、茶、红酒、全谷食品中的植酸和草酸等。因此,在食用这些食物的同时,尽量不要与富含铁质的食物一起摄入。
-
补充铁剂:如果饮食中的铁摄入不足或无法通过饮食改善,可以在医生的指导下补充铁剂。
-
避免过度损失铁:女性经期时会有一定量的铁丢失,可以通过使用卫生棉条或月经杯减少对铁的损失。
-
保持健康的消化系统:一些肠道疾病、手术或药物使用可能会影响铁的吸收。保持消化系统的健康,可以帮助身体更好地吸收和利用铁。
-
定期体检:定期进行体检,特别是血液检查,可以及早发现和治疗贫血,包括缺铁性贫血。
请注意,如果怀疑自己患有缺铁性贫血或其他健康问题,请咨询医生的建议和指导。
原文地址: https://www.cveoy.top/t/topic/h3qf 著作权归作者所有。请勿转载和采集!